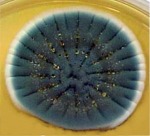

| Do you really have a mold problem? | |||||||||
|
|
|||||||||
| Evaluation of airborne mold spore problems | |||||||||
|
|
Air sampling - viable and non-viable | ||||||||
|
|
Surface sampling - viable and non-viable | ||||||||
|
|
Hidden source sampling | ||||||||
|
|
Identification of environmental mold samples | ||||||||
|
|
Recognition of the synergistics of airborne microbes | ||||||||
|
|
|||||||||
| Determination of the source/cause of mold spore contamination | |||||||||
|
|
Moisture problems | ||||||||
|
|
Ventilation | ||||||||
|
|
Introduced source | ||||||||
|
Recommendations for remediation |
|||||||||
|
|
By building owner | ||||||||
|
|
By remediation professionals | ||||||||
|
Photomicrographs: |
|||||||||
|
|||||||||
 |
| Typical air sampler |
 |
| Cladosporium on wood |
 |
| Stachybotrys
chartarum on plaster
board (aka Black Mold) |
|
| Penicillium sp. agar plate |
| Copyright © 2004-2012 Fungal & Decay Diagnostics, LLC |


